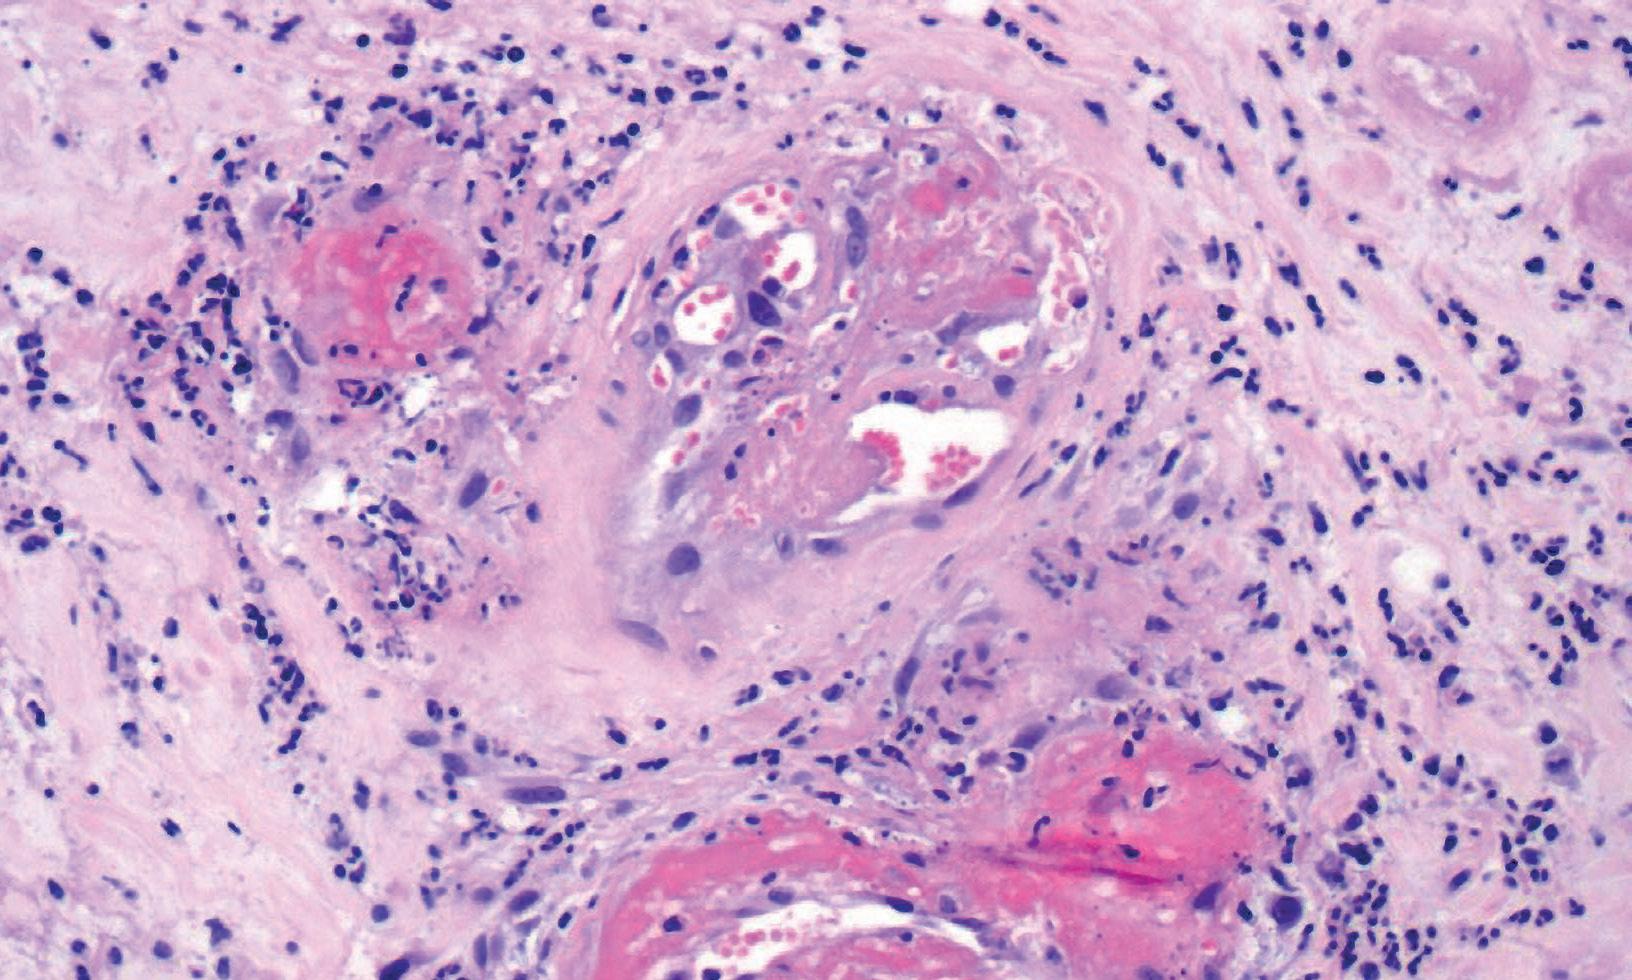

Leishmaniosis y Dirofilariosis:
Retos diagnósticos y terapéuticos a través de casos clínicos
Reservados todos los derechos.
Queda prohibida la reproducción parcial o trasmisión en alguna forma, sin la autorización expresa del propietario y los autores.
Advertencia:
La ciencia veterinaria está sometida a constantes cambios evolutivos, del mismo modo que la farmacología y el resto de las ciencias también lo están. Así pues, es responsabilidad ineludible del veterinario clínico, basándose en su experiencia profesional, la determinación y comprobación de la dosis, el método, el periodo de administración y las contraindicaciones de los tratamientos aplicados a cada paciente.
Ni Fatro Ibérica S.L. ni los autores asumen responsabilidad alguna por la dosis o perjuicios que pudieran generarse a personas, animales o propiedades como consecuencia del uso o la aplicación correcta o incorrecta de los datos que aparecen en este libro.
Publicado y distribuido por:
© 2023 Fatro Ibérica S.L
Constitución 1 PB 3
08960. Sant Just Desvern Barcelona (España) www.fatroiberica.es
Autores:
Sergio Villanueva-Saz, Luis Martínez Lostao, Andrés Yzuel Estévez, Antonio Fernández Casasnovas, Maite Verde Arribas, Víctor Martín Santander, Cristina Pérez Sala, María Eugenia Lebrero Berna, Julio Sebastián Pueyo, Ana González Inglán, Álex Gómez Calvo, LLuís Luján Lerma, Jacobo Giner Audivert, Asier Basurco Pérez, Diego López-Sahuquillo, María Amparo Ortuñez Navarro, Estela Pérez Rodríguez, Francisca Roselló Rigo, Héctor Ruiz Pérez, Delia Lacasta Lozano, Ester Yarza Ortíz, María Victoria Martínez Alfonso, Cristina Muñoz Blasco, Maria Borobia Frías
Coordinador del libro:
Sergio Villanueva-Saz
Ilustrador, diseño y compaginación:
Fernando San Mateo Gil
ISBN 978-84-09-47658-9
Impreso en España
Resumen del libro
Este libro se ha elaborado a partir de los archivos de casos clínicos de leishmaniosis y dirofilariosis cardiopulmonar de los autores que han colaborado y que trabajan en diferentes áreas geográficas de España. Se incluyen trece casos de leishmaniosis y de cuatro casos de dirofilariosis cardiopulmonar.
En esta recopilación se ha intentado seleccionar historias clínicas singulares, con presentaciones clínicas atípicas, con respuestas anómalas a los fármacos habitualmente utilizados, o con enfermedades concomitantes. El objetivo ha sido aportar al clínico veterinario información que le permita manejar con más seguridad el proceso diagnóstico y el tratamiento de estas patologías que siempre necesitan una medicina “personalizada”, ajustada a las características del paciente.
En el apartado de leishmaniosis (trece casos) se presentan cuadros clínicos que se pueden considerar clásicos como los oftalmológicos y los osteoarticulares; así como otros de presentación atípica como la aparición de leishmaniosis activa concomitante con enfermedades alérgicas o autoinmunes, que representan un verdadero desafío para el veterinario, que tiene que seleccionar fármacos, que no utilizaría en una situación de leishmaniosis clásica.
El control de la evolución de la enfermedad es otro reto, que bien manejado nos puede garantizar éxitos en situaciones críticas. En este libro se aportan experiencias en este sentido que esperamos sirvan de ayuda a la clínica diaria.
Si bien leishmaniosis es una enfermedad muy anclada en la especia canina, están incrementando los casos en otras especies de compañía como sucede con los gatos y los hurones, por ello hemos incluido tres casos de leishmaniosis en estas especies, que esperamos sirven de faro que aporte claridad en el diagnóstico y tratamiento a este nivel, menos habitual para los clínicos.
Respecto a la dirofilariosis cardiopulmonar, se incluyen tres casos de dirofilariosis canina y uno de dirofilariosis felina. En todos los casos de dirofilariosis, tanto en el diagnóstico como en el tratamiento, se siguen los protocolos de manejo indicados por las actuales guías científicas de referencia. A diferencia de la enfermedad en el perro, la dirofilariosis felina es muy poco frecuente, pero se aporta un caso identificado en nuestras latitudes y el lector podrá obtener información clara de cómo abordar esta patología en casos de sospecha.
Esperamos que esta pequeña obra sea de interés científico y muy útil en la práctica clínica diaria.
Los autores
Deficiencia selectiva de IgA con presencia de un pico policlonal en la fracción beta del proteinograma
RESUMEN › Perra cruzada, hembra entera de 1 año de edad que acude a consulta por apatía, letargia, epistaxis unilateral de dos meses de duración y presencia de dermatitis ulcerativa bilateral en los bordes de los pabellones auriculares.
Las alteraciones de laboratorio que se detectaron fueron anemia e hiperglobulinemia con un presunto pico policlonal en la fracción beta del proteinograma. Como prueba de confirmación de la infección por Leishmania infantum, se utilizó la técnica ELISA, detectándose altos niveles de anticuerpos anti-Leishmania. Como protocolo de tratamiento anti-Leishmania se utilizó antimoniato de meglumina en combinación con alopurinol, comprobándose una reducción de los niveles de anticuerpos a través de la realización de la dilución seriada, así como una disminución de la concentración proteína C reactiva durante el período de tiempo en que se administró el antimoniato de meglumina.
En la paciente se detectó una buena respuesta clínica inicial al tratamiento frente a la leishmaniosis. En base a este caso clínico, la medición de los niveles de anticuerpos anti-Leishmania mediante serología cuantitativa puede resultar útil a corto plazo, ya que el uso de una técnica de dilución seriada doble se correlaciona con la respuesta clínica.
INTRODUCCIÓN
› La leishmaniosis canina es una enfermedad zoonótica causada por Leishmania infantum. Los signos clínicos más típicos asociados a la enfermedad incluyen linfadenomegalia, lesiones cutáneas, anorexia y lesiones oculares.1 Las alteraciones de laboratorio más típicas detectadas son una elevación importante de proteínas totales y globulinas, junto a una alteración del perfil electroforético sérico, siendo la gammapatía policlonal el patrón electroforético más común observado en perros con leishmaniosis.2
Las proteínas de fase aguda (PFAs) son proteínas que cambian su concentración en suero en respuesta a estímulos inflamatorios. Estas proteínas podrían dividirse en PFA positiva (proteína C reactiva (CRP), amiloide sérico A, haptoglobulina, ceruloplasmina,
PRESENTACIÓN DEL CASO
› Es una perra mestiza entera de 1 año de edad con antecedentes de epistaxis unilateral mantenida en el tiempo desde hace cuatro meses, la cual vivía en una
α2-macrogloublina, α1-ácido glicoproteína, fibrinógeno y complemento) basada en una concentración sérica elevada ante estímulo inflamatorio o, por el contrario PFA negativa (albúmina, transferrina, transtiretina, proteína de unión al retinol y adiponectina) que se caracterizan por una disminución de su concentración sérica ante un estimulo.3
Algunos de estas PFAs se consideran biomarcadores para el seguimiento de la respuesta al tratamiento en diferentes enfermedades incluyendo la leishmaniosis canina. Entre estas PFAs, la CRP es la proteína con un aumento más importante en la concentración sérica cuando hay signos de inflamación en el perro.4 En la leishmaniosis canina, se ha descrito una elevación en la CRP y haptoglobulina en animales con una infección activa. Por otro lado, después de administrar un tratamiento anti-Leishmania, se puede detectar una disminución de la CRP.5
Para el tratamiento de la leishmaniosis clínica se han descrito dos protocolos terapéuticos diferentes incluyendo la utilización del antimoniato de meglumina o miltefosina, pero en ambos protocolos siempre en combinación con alopurinol.6
En ambos protocolos, se recomienda la monitorización y seguimiento del paciente durante y después del tratamiento anti-Leishmania considerando tener en cuenta diferentes parámetros de laboratorio como hemograma, perfil bioquímico, electroforesis de las proteínas séricas y análisis de orina después del primer mes de tratamiento y luego cada 3-4 meses. Tradicionalmente, la serología no se recomienda realizar antes de haber transcurrido 6 meses del tratamiento anti-Leishmania inicial,6 debido a la falta de correlación entre los niveles de anticuerpos y la mejora del estado clínico.7
zona endémica de leishmaniosis. En el examen físico, la perra estaba en buenas condiciones, activa y alerta, normotérmica e hidratada. La auscultación cardiopulmonar era normal y no presentaba alteraciones digestivas. Las únicas alteraciones que se detectaron fueron la presencia de linfadenomegalia generalizada y junto con una
leve dermatitis exfoliativa generalizada, sobre todo a nivel dorso lumbar.
La paciente estaba perfectamente vacunada y desparasitada internamente, pero a nivel de desparasitación externa, algunos meses no estuvo protegida con repelentes frente a vectores transmisores.
Pruebas realizadas
› Una vez recogida la historia clínica del paciente se decidió la realización de las siguientes pruebas de laboratorio con hematología, una bioquímica y CRP. Se realizó también análisis de orina (densidad urinaria y el análisis del sedimento urinario).
Teniendo en cuenta que la leishmaniosis canina es una de las enfermedades más prevalente en nuestro entorno y que cursa con lesiones cutáneas, epistaxis y elevación de proteínas totales, era necesario descartar a L. infantum mediante una serología cuantitativa ELISA.8 El punto de corte de esta técnica era de 30 Unidades ELISA (UE).
La muestra de suero con valores de UE ≥ 200 se clasificaba como positivo alto, suero con un valor UE ≥ 100 y < 200, se clasificaba como positivo medio y finalmente suero con un valor UE > 30 y < 100 se clasificaba como positivo bajo. Todas las muestras de suero con una densidad óptica igual o mayor de 3 se realizó dilución seriada.9
Los resultados de laboratorio revelaron un aumento de las proteínas totales, hiperglobulinemia, anemia y elevación de la CRP. El resto de los parámetros bioquímicos estaban dentro de los rangos de referencia. El análisis de orina no mostró anomalías. También se realizó electroforesis de las proteínas séricas para investigar la naturaleza
de la hiperglobulinemia. La electroforesis reveló pico en la fracción beta (Figura 1).
Por otro lado, se identificaron las bandas de proteínas que formaban las diferentes regiones electroforéticas mediante inmunofijación electroforética (IFE), siendo un método muy específico para identificar la ubicación exacta de las proteínas.10 No se observó banda monoclonal en ninguna de las tres inmunoglobulinas principales analizadas (IgA, IgG e IgM), clasificándola como patrón policlonal compuesto por IgM e IgG y la ausencia de IgA (Figura 2). Finalmente, se cuantificaron los niveles de inmunoglobulinas IgG, IgA e IgM en las muestras séricas mediante nefelometría. IF 2/4
Figura 2. ▲
| Figura 1. ▲
Electroforesis en gel de agarosa. Se detecta un pico policlonal en la fracción beta.
Caracterización proteica mediante inmunofijación previa al tratamiento. Se detecta un patrón policlonal compuesto por IgM e IgG.
DIAGNÓSTICO
diferencial
› En perros hay diferentes patologías que pueden producir una situación de hiperglobulinemia.10 Esta alteración podría ser el resultado de aumentos en una o todas las fracciones de proteínas séricas incluyendo α-globulinas, β-globulinas y γ-globulinas. En el presente caso, el perfil electroforético fue muy útil para caracterizar la hiperglobulinemia con la presencia de una betagammopatía policlonal que acompa-
ñaba una elevación en γ-globulinas como consecuencia de la estimulación antigénica asociada a L. infantum. Esta situación podría explicarse porque las inmunoglobulinas IgA, IgM y subclases de IgG son capaces de migrar a la fracción β-globulina. Las causas más comunes de gammapatía policlonal son enfermedades inflamatorias (infecciosas, inmunomediadas), enfermedades hepáticas, dermatopatías supurativas.
El diagnóstico diferencial de dermatitis ulcerativa 11-13 incluye enfermedades infecciosas (leishmaniosis, pioderma bacteriana mucocutánea),
enfermedades inmunomediadas (dermatitis por picadura de mosca, pénfigo y dermatosis subepidérmica bullosa, lupus eritematoso cutáneo y sistémico, vasculitis idiopática, enfermedad por aglutininas frías, necrosis trombovascular proliferativa del pabellón auricular, arteritis proliferativa del filtrum nasal, dermatitis necrótica superficial, síndrome uveodermatológico, dermatomiositis, dermatosis actínica) medicamentos (reacciones adversas), causas ambientales (congelación), causa nutricional (dermatosis sensible al Cinc) y tumor cutáneo (linfoma cutáneo epiteliotrópico).
TRATAMIENTO
› El tratamiento se centró en la causa de la patología, que es un perro con leishmaniosis clínica. El protocolo terapéutico fue a base de alopurinol (10 mg/kg/12 horas vía oral) y antimoniato de meglumina (40 mg/kg/12 horas vía subcutánea durante 5 semanas). El paciente no requirió ningún otro tratamiento.
Se estableció un protocolo terapéutico con antimoniato de meglumina durante tres semanas a dosis crecientes cada semana para controlar los posibles efectos adversos del medicamento de 25 mg/kg/12 horas la primera semana a 40 mg/kg/12 horas la tercera, cuarta y quinta semana subcutáneamente. 6,14
Deficiencia selectiva de IgA con presencia de un pico policlonal en la fracción beta del proteinograma
EVOLUCIÓN CLÍNICA
› La epistaxis se resolvió en 15 días después de comenzar el tratamiento anti-Leishmania, mientras que la dermatitis ulcerativa en bordes auriculares se resolvió dos meses más tarde (día 125). Se realizaron visitas de seguimiento durante el período de tratamiento con antimoniato de meglumina. Cuatro meses después de completar este tratamiento con antimoniato de meglumina, se realizó una visita de seguimiento al veterinario, incluyendo un examen físico y pruebas de laboratorio como hematología, bioquímica y proteinograma sérico (Tabla 1).
Además, el proteinograma detectó un patrón normal del perfil (Figura 3) con presencia de patrón IgG detectado por IFE (Figura 4).
Electroforesis en gel de agarosa en el día 185. La electroforesis reveló un patrón de proteínas séricas normal.
Figura 4. ▲
Caracterización de proteínas mediante inmunofijación tras tratamiento al día 185. Se detectó un patrón de IgG.
Valores hematológicos, bioquímicos y serológicos del paciente en el momento del diagnóstico y durante su seguimiento postratamiento.
ABREVIATURAS:
A/G: Ratio albúmina: globulina
ALT: Alanina aminotransferasa
ALKP: Fosfatasa alcalina
BUN: Nitrógeno ureico en sangre
CHCM: Concentración de hemoglobina corpuscular media
GGT: Gamma-glutamil transferasa
HCM: Hemoglobina corpuscular media
Ig: Immunoglobulina
VCM: Volumen corpuscular medio
RDW: Amplitud de distribución eritrocitaria
**: Valor no disponible
- : Negativo
Tabla 1. ▶
Figura 3. ▲
Intervalos
HEMATOLOGÍA
BIOQUÍMICA
de un pico policlonal en la fracción beta del proteinograma
DISCUSIÓN
› La deficiencia de inmunoglobulina selectiva A (DSIgA) es la clase más prevalente de inmunodeficiencia primaria en seres humanos y perros.15 En seres humanos, esta inmunodeficiencia selectiva puede ser asintomática o, por el contrario, la presencia de síntomas que pueden ser de leves a graves, incluyendo infecciones respiratorias, infecciones gastrointestinales, enfermedades autoinmunes
Esta patología se describió por primera vez a principios de la década de 1960,16 y veinte años después, la presencia de esta DSIgA se diagnosticó en perros.17 Es importante señalar que las concentraciones de IgA varían ampliamente entre las razas, lo que explica la falta de un rango de referencia de diagnóstico generalmente aceptado para la deficiencia de IgA en perros.18
Sin embargo, en el presente caso, la técnica del IFE determinó la ausencia de patrón de IgA antes del tratamiento y después del tratamiento en el día 185 (Figura 4). Además, los niveles de IgA fueron inferiores al límite de detección antes y después del tratamiento (Tabla 1).
◀ Figura 5.
Paciente en el día 185. Ausencia de signos clínicos compatibles con la enfermedad.
En general, los trastornos de inmunodeficiencia canina están menos caracterizados y se dispone de menor información clínica en comparación con medicina humana. Se describen dos tipos diferentes de inmunodeficiencias caninas: la inmunodeficiencia primaria asociada a cachorros y la inmunodeficiencia típicamente relacionada con la raza o secundaria en adultos. La inmunodeficiencia secundaria en los perros es una consecuencia de una variedad de causas, incluyendo drogas, trastornos neoplásicos, enfermedades infecciosas, enfermedades inflamatorias y
alérgicas, entre otras posibles causas. En humanos y perros, estos trastornos se asocian con una mutación en el gen que codifica la cadena alfa de la Ig, detectándose una concentración relativamente baja en las zonas mucosas o en el suero.19,20
La leishmaniosis canina es capaz de comprometer la respuesta inmune del perro, lo que lo hace susceptible a otras coinfecciones y/ o trastornos.21
La coexistencia de Leishmania y una DSIgA no se ha descrito en la literatura científica. En este sentido, es difícil establecer la relación causa-efecto. Si la DSIgA es consecuencia de la presencia del parásito o, por el contrario, la inmunodeficiencia selectiva puede predisponer a un aumento de la susceptibilidad a la infección.
Algunos factores como la raza, enfermedades concomitantes (enfermedades infecciosas, neoplasias, endocrinopatías), el estado de inmunosupresión y los factores nutricionales pueden influir directamente en la susceptibilidad a la infección.22 Aunque no es posible explicar la relación entre la enfermedad parasitaria y la deficiencia de inmunoglobulina selectiva, los perros con alguno tipo de inmunodeficiencia podrían ser más susceptibles a la infección por Leishmania. En este paciente,
la DSIgA no fue secundaria a la infección parasitaria porque seis meses después de la presentación clínica, no se habían detectado signos clínicos o anomalías clinicopatológicas, excepto por el hecho de que el perro seguía presentando esta deficiencia selectiva.
La relación entre la presencia de IgA anti-Leishmania y los perros que sufren leishmaniosis clínica se ha evaluado en muestras de orina y suero.23 El papel de la IgA se asocia a la inmunología de la mucosa como primer nivel de protección en las secreciones mucosas. La ausencia de IgA en muestras de suero podría favorecer la presencia del parásito en áreas mucosas incluyendo cavidad nasal con la aparición de lesiones y por tanto signos clínicos como epistaxis.
Tradicionalmente, la serología cuantitativa no se recomendaba antes de los 6 meses posteriores al tratamiento inicial frente al parásito.Sin embargo, recientes evidencias científicas confirman que es posible detectar una reducción temprana del nivel de anticuerpos anti-Leishmania después de 30 días después de la primera inyección de antimoniato de meglumina. En nuestro caso, se detectó una marcada reducción de estos anticuerpos durante la administración del antimonia-
to de meglumina cuando se utilizó la dilución seriada en comparación con la realización de una única dilución en el análisis ELISA. La razón de esta diferencia entre una única dilución y el método de dilución seriada se debe en el primer caso, a que una elevada concentración de anticuerpos anti-Leishmania se encuentran presentes en la muestra. Esta circunstancia produce una saturación de la señal en la técnica ELISA, mientras que el uso de diluciones de muestra mediante el método ELISA de dilución seriada disminuye la cantidad de anticuerpos anti-Leishmania evitando los límites de la técnica ELISA. La reducción del nivel de anticuerpos durante la administración de antimoniato de meglumina se correlacionó con el curso clínico y los hallazgos de laboratorio como la CRP.
El uso de la CRP como biomarcador en la leishmaniosis canina se ha evaluado en perros sometidos a tratamiento de leishmaniosis.24 La medición de esta PFA podría ser de interés porque podría ayudar a veterinarios a tomar decisiones durante el seguimiento. La reducción de la concentración de CRP es un parámetro de laboratorio que puede ayudar a los veterinarios a evaluar la respuesta a la terapia a corto plazo, junto con la serología cuantitativa.